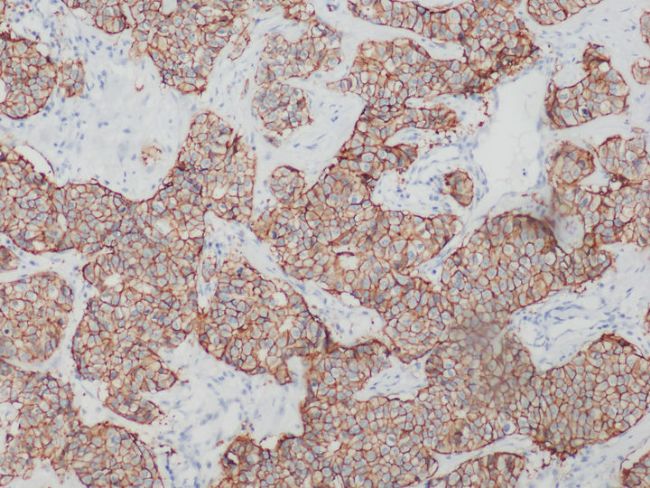

ҹЙ№вп@ОўзR‘ӘУГУЪИйПЩ°©HER2ҷzңy
HERКЗТ»оҗЕcјҡ°ыФцЦіПўПўПакPөДө°°ЧЩ|Ј¬И«·QКЗhuman epidermal growth factor receptorЈ¬ЦРОДҪРЧчИЛұнЖӨЙъйLТтЧУКЬуwЎЈHERө°°ЧЩ|јТЧе№ІУРЛДРЦөЬЈ¬ЖдЦРHER2Ш“ШҹҢўјҡ°ыДӨНвөДЙъГьРЕПўӮчҢ§ЦБјҡ°ығИЈ¬КЗИйПЩ°©Ф\”аЦёҳЛЦ®Т»Ј¬ҷzңyHER2Т»°гУГХэЦГҹЙ№вп@ОўзRЈ¬К№УГГвТЯҪM»Ҝ»тҹЙ№вФӯО»лsҪ»FISHјјРgЎЈ

ФЪИйПЩ°©Ј¬Оё°©өИД[БцәYІйоIУтЦРЈ¬HER2өДұнЯ_Л®ЖҪКЗД[БцҷzңyөДіЈУГЦёҳЛЎЈДҝЗ°Ј¬HER2»щТтҷzңyіЈТҠ·ҪКҪТФГвТЯҪM»ҜIHCјјРgәНFISHјјРgһйЦчЎЈ

ГвТЯҪM»ҜHER2ҷzңyҝЙТФУГЖХНЁп@ОўзRГчҲцУ^ІмҢҚ¬FЈ¬ФOӮдТӘЗуЭ^өНЈ¬ө«м`Гф¶ИәНМШ®җРФПаҢҰИхЎЈ

ФЪИйПЩ°©HER2»щТтҷzңyЦРЈ¬ҹЙ№вФӯО»лsҪ»ЈЁFISHЈ©јјРgУРёьёЯөДҷzңyңКҙ_ВКЎЈ

ҹЙ№вФӯО»лsҪ»јјРgЈ¬ЖдФӯАн»щУЪүA»щ»ҘСaЕдҢҰөДФӯ„tЈ¬НЁЯ^ҢҰҪMҝ—ҳУЖ·МШКвМҺАнК№Һ§УРҹЙ№вОпЩ|өДМҪбҳЕcДҝҳЛDNAҪУәПЈ¬ЧоәуУГMF43-NөИХэЦГҹЙ№вп@ОўзRёЯұ¶·ЕҙуЦұҪУУ^ІмДҝҳЛDNAЛщФЪөДО»ЦГЈ¬Ф“јјРgҸV·ә‘ӘУГУЪД[БцІЎАнФ\”аЎў»щТт¶ЁО»ЎўИҫЙ«уwСРҫҝөИоIУтЎЈ

ГчГАMF43-NХэЦГҹЙ№вп@ОўзRҝЙЯxҙоЕдёЯм`Гф¶ИҹЙ№вПаҷCәНMFISHҲDПс·ЦОцПөҪyЈ¬ АыУГҹЙ№в»щҲFҳЛУӣDNAМҪбҳЈ¬ФЩҢўҳЛУӣөДDNAМҪбҳЕcҳУұҫDNAЯMРРФӯО»лsҪ»Ј¬ФЪҹЙ№вп@ОўзRПВҢҰҹЙ№вРЕМ–ЯMРРУӢ”өЈ¬һйЕRҙІФ\”аМṩТА“юЎЈ
ГвШҹВ•Гч
ұҫХҫҹo·Ёиb„eЛщЙПӮчҲDЖ¬ЎўЧЦуw»тОДЧЦғИИЭөД°жҷаЈ¬ИзҹoТвЦРЗЦ·ёБЛДДӮҖҷаАыИЛөДЦӘЧR®aҷаЈ¬ХҲҒнРЕ»тҒнлҠёжЦ®Ј¬ұҫХҫҢўБўјҙУиТФ„hіэЈ¬ЦxЦxЎЈ
ҒнФҙЈәhttps://www.mshot.com/news/30.html

ГвТЯҪM»ҜHER2ҷzңyҝЙТФУГЖХНЁп@ОўзRГчҲцУ^ІмҢҚ¬FЈ¬ФOӮдТӘЗуЭ^өНЈ¬ө«м`Гф¶ИәНМШ®җРФПаҢҰИхЎЈ

ФЪИйПЩ°©HER2»щТтҷzңyЦРЈ¬ҹЙ№вФӯО»лsҪ»ЈЁFISHЈ©јјРgУРёьёЯөДҷzңyңКҙ_ВКЎЈ

ҹЙ№вФӯО»лsҪ»јјРgЈ¬ЖдФӯАн»щУЪүA»щ»ҘСaЕдҢҰөДФӯ„tЈ¬НЁЯ^ҢҰҪMҝ—ҳУЖ·МШКвМҺАнК№Һ§УРҹЙ№вОпЩ|өДМҪбҳЕcДҝҳЛDNAҪУәПЈ¬ЧоәуУГMF43-NөИХэЦГҹЙ№вп@ОўзRёЯұ¶·ЕҙуЦұҪУУ^ІмДҝҳЛDNAЛщФЪөДО»ЦГЈ¬Ф“јјРgҸV·ә‘ӘУГУЪД[БцІЎАнФ\”аЎў»щТт¶ЁО»ЎўИҫЙ«уwСРҫҝөИоIУтЎЈ

ГчГАMF43-NХэЦГҹЙ№вп@ОўзRҝЙЯxҙоЕдёЯм`Гф¶ИҹЙ№вПаҷCәНMFISHҲDПс·ЦОцПөҪyЈ¬ АыУГҹЙ№в»щҲFҳЛУӣDNAМҪбҳЈ¬ФЩҢўҳЛУӣөДDNAМҪбҳЕcҳУұҫDNAЯMРРФӯО»лsҪ»Ј¬ФЪҹЙ№вп@ОўзRПВҢҰҹЙ№вРЕМ–ЯMРРУӢ”өЈ¬һйЕRҙІФ\”аМṩТА“юЎЈ
ГвШҹВ•Гч
ұҫХҫҹo·Ёиb„eЛщЙПӮчҲDЖ¬ЎўЧЦуw»тОДЧЦғИИЭөД°жҷаЈ¬ИзҹoТвЦРЗЦ·ёБЛДДӮҖҷаАыИЛөДЦӘЧR®aҷаЈ¬ХҲҒнРЕ»тҒнлҠёжЦ®Ј¬ұҫХҫҢўБўјҙУиТФ„hіэЈ¬ЦxЦxЎЈ
ҒнФҙЈәhttps://www.mshot.com/news/30.html
°lІјХЯЈәҸVЦЭКРГчГА№влҠјјРgУРПЮ№«Лҫ
В“ПөлҠФ’Јә020-38250606 38262481 400-880-1910
E-mailЈәmshot@mshot.com
В“ПөлҠФ’Јә020-38250606 38262481 400-880-1910
E-mailЈәmshot@mshot.com
- PCO CCDПаҷCЦъБҰМбёЯ”өЧЦБЈЧУҲDПсңyЛЩ(DPIV)өДёДЯMјјРgР§ВК
- MSHПөБРұіХХКҪПаҷCөДМШьcғһ„ЭЕcЖдФЪҝЖСРЕc№ӨҳIіЙПсЦР‘ӘУГ
- INTEGOөДёЯ¶И¶ЁЦЖ»ҜПөҪyЦъБҰДЈүK»ҜЖ·ҲAҷzңy
- pco.edge 4.2 bi UVПаҷCФЪұЎДӨ·ЦОцЦРөД‘ӘУГ
- Т»·N„“РВіЙПс№ЬөАЈәӯh·ҙҫн·eп@ОўзRҢҚ¬FұгҪЭёЯР§өДҝХйgЧғ»ҜПсІоРЈХэ
- К§ЛЩ¶МЕ“ЯMҡвөАғИөДБч„УСРҫҝЈәSPIVңyБҝәН•rйgЖҪҫщмoүәңyБҝ
- ёЯ·ЦұжВКIMCРВјјРgҢҚ¬FөНУЪ350ј{ГЧөД·ЦұжВК
- Т»н—ҪYәПЛЩ¶Иғһ»ҜөДDNAзRПсРтБРіЙПсРВІЯВФҢҚ¬FёЯР§12ЦШі¬·ЦұжіЙПс
- і¬ҫSҫ°іЙ№ҰИлЯx2025ДкЎ¶Ш”ё»Ў·23јТҙуҪЎҝөЖуҳI°сҶО
- °ЈЩҗБҰЯ_ҝЖјјpco.panda 26 DS sCMOSПаҷCРВЖ·ЙПКР
- °ЈЩҗБҰЯ_ҝЖјјНЖіцРВЖ·pco.panda 4.2 bi sCMOSПаҷC
- ІМЛҫЕcј{Т•ҫ«ОўәһКр‘рВФәПЧчТвПтЈ¬НЖ„УҮш®aғxЖч„“РВ
- ЖЖҫЦ”ө“юәйБчЈ¬ІМЛҫarivis 4.4°жұҫёьРВAIёЯғИәӯ·ЦОц
- і¬ҫSҫ°»оуwіЙПсПөҪyөИҢўББПа2025ГАҮшЙсҪӣҝЖҢWДк•ю
- і¬ҫSҫ°іЙПс·Ҫ°ёҫ«ІКББПаHICOOL 2025И«Зт„“ҳIХЯ·е•ю
- ӯhҒҶЙъОпҫ«ІКББПаЦШ‘cЙсҪӣҝЖҢWҢW•юДzЩ|јҡ°ы·Ц•ю
Copyright(C) 1998-2025 ЙъОпЖчІДҫW лҠФ’Јә021-64166852;13621656896 E-mailЈәinfo@bio-equip.com






